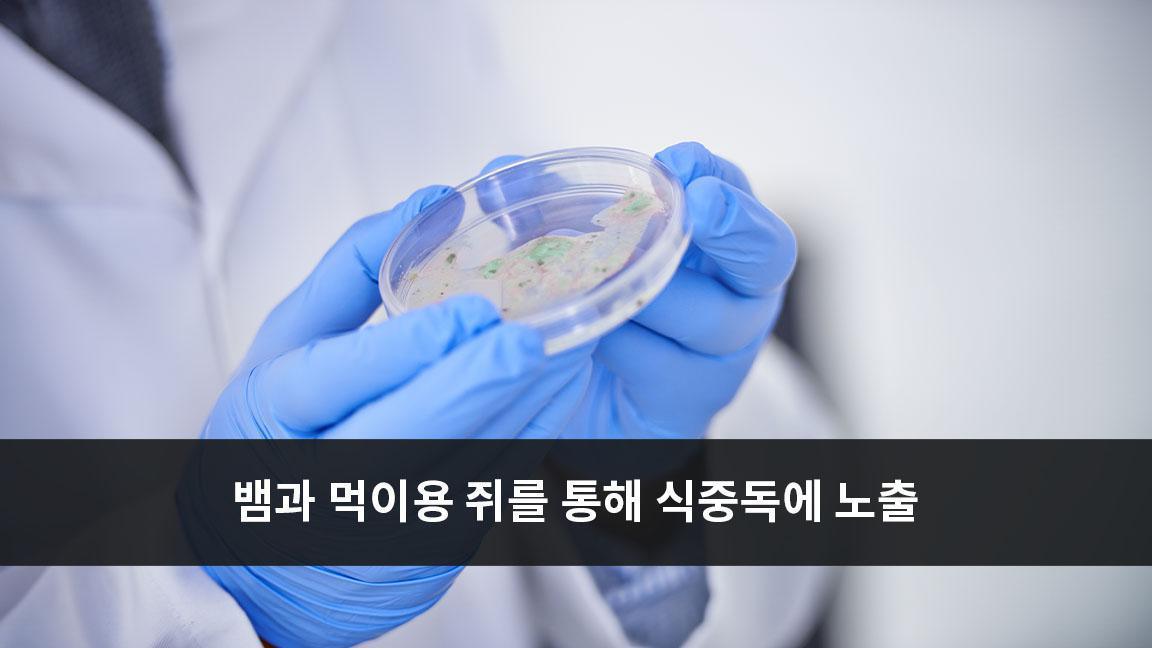
뱀과 먹이용 쥐를 통해 식중독에 노출 뱀과 먹이용 쥐를 통해 식중독에 노출

캐나다 공중보건국은 약 2년 전에 시작된 살모넬라균으로 인한 식중독 발병이 뱀 과 먹이용 쥐로 인한 것인지에 대한 연관성을 조사하고 있다고 밝혔습니다.
연방 정부 공중보건부는 3월 19일 현재 이번 살모넬라균 집단 발병의 확진자는 70명이라고 밝혔습니다.
캐나다 공중 보건국은 "10명이 병원에 입원했습니다. 한 명이 사망했고 주 공중 보건 파트너들은 살모넬라균이 사망의 원인임을 확인했습니다."라고 보도 자료를 통해 발표했습니다.
2022년 2월과 2024년 2월 까지 BC, 앨버타, 서스캐처원, 매니토바, 온타리오, 퀘벡, 뉴브런즈윅, 뉴펀들랜드와 래브라도 주에서 위와 같은 사례들이 확인되었습니다.
관계자들은 식중독에 걸린 사람들 중 많은 수가 동물들과 직간접적으로 접촉을 했다고 말했습니다. 일부는 뱀이나 설치류를 직접 만지지는 않았지만, 그들이 사육되는 곳과 같은 집에서 살았습니다.
살모넬라균 식중독과 관련된 뱀이나 먹이용 쥐의 공급자는 아직 확인되지 않았습니다.
지난해 봄 전국적으로 살모넬라균 발생이 증가하면서 처음 조사가 시작됐습니다.
유전자 시퀀싱 결과 2022년에 발생한 사례가 2023년과 2024년에 보고된 사례에서 확인된 것과 동일한 균주에 의해 발생한 것으로 나타났습니다.
식중독 증상은 보통 살모넬라균에 노출된 후 6시간에서 72시간 사이에 발생합니다. 증상으로는 발열, 구토, 두통, 복부 경련 등이 있을 수 있습니다.
"파충류와 설치류, 그들의 먹이, 환경을 만진 다음 손을 씻지 않고 얼굴, 눈, 입을 만지면 살모넬라균에 감염될 수 있습니다."라고 보건부는 경고하며 아이들도 여러 행사나 동물원, 파충류 쇼 등을 통해 살모넬라균에 노출 될 수 있다고 덧붙였습니다.